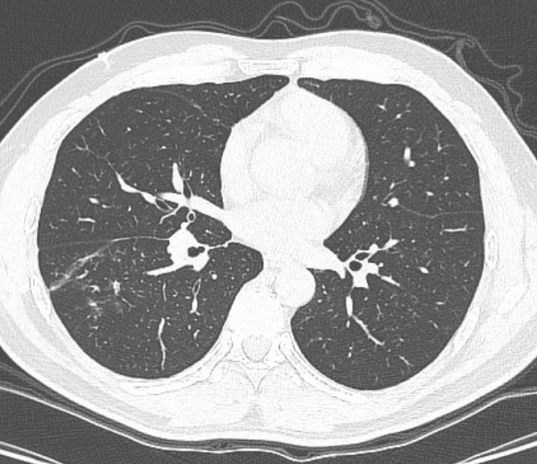

一次日常用餐意外,引发持续高热、咳嗽难愈;一场多环节紧密配合的救治,成功化解气道危机!近日,广西科技大学第一附属医院呼吸与危重症医学科团队以高度负责的职业态度、默契高效的协作精神、精湛成熟的内镜技术,为一名误吸异物的患者精准解除险情,用专业与担当守护患者生命健康。
小小酸豆角,竟成气道“堵点”
42岁的市民陈先生在食用米粉时不慎呛咳,起初并未在意,可随后反复呛咳、持续高热轮番来袭,常规对症治疗始终不见起色,病情日渐加重。焦急之下,陈先生来到我院呼吸与危重症医学科就诊。科室团队高度重视、细致研判,胸部CT提示右下肺炎症,结合明确的呛咳病史,团队快速精准判断:气道内极有可能藏着“作祟”的异物,这正是久治不愈的根源!从接诊评估、影像读片,到方案制定、术前准备,科室团队分工明确、衔接顺畅,为快速救治筑牢基础。
住院次日,黄善珊主治医师在团队协作支持下,为患者实施电子支气管镜检查。镜下真相令人心惊:右下叶支气管内布满痰栓,一段异物深深嵌顿在右下叶前基底段,被分泌物紧紧包裹。若再不及时取出,极易引发气道完全阻塞、窒息等危及生命的严重后果。凭借团队扎实的技术功底与默契配合,黄善珊主治医师精准定位、轻巧操作,将异物完整取出——众人意外发现,这枚“元凶”竟是一小段酸豆角!

纤支镜检查术医护团队

纤支镜下见:右下叶支气管大量脓痰

纤支镜下:右下叶前基底段支气管异物堵塞
精研“镜技”,妙手取物护气道
异物取出后,困扰陈先生多日的咳嗽、高热迅速缓解。科室团队全程跟进,制定规范个体化的后续治疗方案,经过1周抗感染治疗,复查CT显示肺部炎症明显吸收;住院第10天,陈先生便顺利康复出院,重归正常生活。“小小一段酸豆角,差点闯下大祸,多亏呼吸科团队及时出手、妙手回春!”出院时,陈先生满是感激与后怕。

取出的异物--“酸豆角”

术前胸部CT
术后抗感染1周后复查的胸部CT
黄善珊主治医师介绍,气道异物是呼吸科常见急症,虽高发于老人与儿童,但成年人因进食时谈笑、分心导致误吸的案例也屡见不鲜。异物滞留气道,会持续刺激黏膜引发炎症,久拖不治可诱发肺不张、重症感染,甚至窒息身亡。他特别强调:有明确呛咳史,且伴随反复咳嗽、发热、肺部感染久治不愈的患者,务必高度警惕气道异物!电子支气管镜作为诊断与治疗的“利器”,可直观探查气道、微创取出异物,创伤小、恢复快、疗效确切,是守护气道安全的关键手段。
此次成功救治,是广西科技大学第一附属医院呼吸与危重症医学科团队专业素养、协作精神与应急救治能力的生动体现。一直以来,科室始终坚持以患者为中心,精研技术、优化流程、团结协作,不断提升急危重症诊疗水平,为群众呼吸健康保驾护航。
温馨提醒
用餐时务必细嚼慢咽,不说笑、不打闹,食用豆类、坚果、米粉配菜时格外小心;一旦发生呛咳,且出现持续咳嗽、胸闷、发热等不适,切勿拖延观望,及时就医,别拖延!
呼吸与危重症医学科专家团队介绍

陆薇
广西科技大学第一附属医院副院长
呼吸与危重症医学科学术带头人、内科住培基地主任
主任医师、在读博士
广西医学会呼吸内镜学分会第四届委员会常务委员、广西医师协会第二届呼吸医师分会常务委员、广西医师协会第一届呼吸医师分会中青年委员会常务委员、广西医学会变态反应学分会第一届青年委员会委员、广西抗癌协会肺癌专业委员会委员、广西临床肿瘤学会(GSCO)第一届肺癌专家委员会委员、广西慢性呼吸疾病医疗专业委员会第一届委员、柳州市医学会睡眠呼吸分会副主任委员、柳州市医学会呼吸内镜学分会副主任委员、柳州市预防医学会呼吸病预防与控制专业委员会副主任委员。从事呼吸内科临床、教学及科研工作10余年,主持并参与科研多项,在国内期刊发表论文十余篇。曾在中国人民解放军总医院进修学习,进修方向为呼吸肿瘤及呼吸介入治疗。曾获得2024年柳州市"百佳医师"称号。
擅长:呼吸系统常见病、多发病以及呼吸危重症的诊断治疗,尤其在慢阻肺、肺癌及呼吸介入治疗方面有丰富的临床经验

覃灏
呼吸与危重症医学科负责人
副主任医师、研究生
柳州市医学会睡眠呼吸分会委员、柳州市医学会呼吸内镜学分会委员、柳州市预防医学会呼吸病预防与控制专业委员会委员
擅长:对各种类型肺癌及呼吸危重症、慢性阻塞性肺疾病、肺栓塞、侵袭性肺真菌病、各种类型肺炎等呼吸系统疾病的诊治。

梁新梅
呼吸与危重症医学科首席专家、主任医师、研究生
广西医师协会呼吸医师协会常委、广西预防医学会呼吸病预防与控制委员会常委、广西医学会呼吸分会委员、广西慢阻肺联盟常委、广西医学会呼吸分会COPD组组员、广西医学会呼吸分会哮喘组组员、柳州市医学会内科分会副主委。
擅长:慢阻肺、支气管哮喘、呼吸危重症、疑难症的诊治,精于有创、无创呼吸机治疗及支气管镜检诊治工作,在慢性咳嗽、肺部结节鉴别诊断有丰富的临床经验。主持参与科研课题4项,发表医学论文10余篇。

吴汉刚
呼吸与危重症医学科副主任医师,副教授
广西医学会呼吸内镜分会委员。1998年开始从事呼吸内科工作。曾到北京协和医院呼吸内科进修学习1年。
擅长:咳嗽的鉴别及治疗、不明原因发热的鉴别、支气管哮喘、慢性阻塞性肺疾病、肺部占位、胸腔积液、肺炎等疾病的诊治,在肺功能检查、纤维支气管镜检查、无创和有创呼吸支持治疗及呼吸急危重症的救治方面有着丰富的临床经验;在区内外发表医学论文数篇。
呼吸与危重症医学科简介

科室概况:设呼吸门诊、普通病房、呼吸重症监护室(RICU)、肺功能室、呼吸内镜室、呼吸睡眠室;集临床、教学、科研和预防保健于一体;拥有一支技术力量雄厚,医术精湛、服务一流的医疗团队;科室开放有普通病床和重症监护病房,现有医生9人,正高职称3人,副高职称3人,主治医师1人,其中在读博士1人、硕士研究生3人、在读研究生1人。科室同时承担临床,住培教学及学校理论与实践教学课程。配备进口奥林巴斯电子支气管镜、德国耶格肺功能仪、有创和无创呼吸机、中央监护系统等先进的医疗设备;诊治呼吸系统的常见病、多发病、疑难病及呼吸急危重症等;在肺结节、肺栓塞、肺部肿瘤和间质性肺疾病等诊治方面积累了丰富的临床经验。
呼吸与危重症学科咨询电话:0772-2699107 0772-2699108
住院病房地点:住院部三号楼三楼
出诊地点:门诊楼二楼呼吸与危重症学科咨询室

